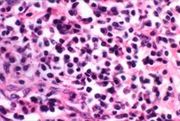

File list
From Otolaryngology Online
This special page shows all uploaded files.
| Date | Name | Thumbnail | Size | User | Description |
|---|---|---|---|---|---|
| 07:18, 23 October 2018 | Flap 3.jpg (file) |  |
30 KB | Drtbalu | |
| 07:17, 23 October 2018 | Flap 2.jpg (file) |  |
26 KB | Drtbalu | |
| 07:17, 23 October 2018 | Flap 1.jpg (file) |  |
27 KB | Drtbalu | |
| 07:05, 23 October 2018 | Pm.jpg (file) |  |
73 KB | Drtbalu | |
| 06:56, 23 October 2018 | Retro 1.jpg (file) |  |
35 KB | Drtbalu | |
| 06:56, 23 October 2018 | Retro ab.jpg (file) |  |
129 KB | Drtbalu | |
| 06:54, 23 October 2018 | Papilloma.jpg (file) |  |
25 KB | Drtbalu | |
| 06:54, 23 October 2018 | Hpv ult.jpg (file) |  |
92 KB | Drtbalu | |
| 06:53, 23 October 2018 | Hpvirus.jpg (file) |  |
39 KB | Drtbalu | |
| 06:51, 23 October 2018 | Resp pap.jpg (file) |  |
53 KB | Drtbalu | |
| 06:15, 23 October 2018 | Quinsy.jpg (file) |  |
69 KB | Drtbalu | |
| 06:14, 23 October 2018 | Pyriform fossa.jpg (file) |  |
35 KB | Drtbalu | |
| 06:07, 23 October 2018 | Pillar 3.jpg (file) |  |
5 KB | Drtbalu | |
| 06:07, 23 October 2018 | Pillar 2.jpg (file) |  |
46 KB | Drtbalu | |
| 06:06, 23 October 2018 | Pillar 1.jpg (file) |  |
62 KB | Drtbalu | |
| 05:50, 23 October 2018 | Phy pouch.jpg (file) |  |
43 KB | Drtbalu | |
| 05:49, 23 October 2018 | Phary pouch.jpg (file) |  |
115 KB | Drtbalu | |
| 05:09, 23 October 2018 | Pms.jpg (file) |  |
16 KB | Drtbalu | |
| 05:01, 23 October 2018 | Fanconi.JPG (file) |  |
43 KB | Drtbalu | |
| 05:00, 23 October 2018 | Rapi trach.jpg (file) |  |
13 KB | Drtbalu | |
| 05:00, 23 October 2018 | Rapitrach.jpg (file) |  |
20 KB | Drtbalu | |
| 04:59, 23 October 2018 | Dilator.jpg (file) |  |
44 KB | Drtbalu | |
| 04:57, 23 October 2018 | Mandi swing.jpg (file) |  |
77 KB | Drtbalu | |
| 04:57, 23 October 2018 | Trans cerv.jpg (file) |  |
30 KB | Drtbalu | |
| 04:56, 23 October 2018 | Paramass mri.jpg (file) |  |
52 KB | Drtbalu | |
| 04:55, 23 October 2018 | Para neckmass.jpg (file) |  |
70 KB | Drtbalu | |
| 04:44, 23 October 2018 | Zellballen.jpg (file) |  |
91 KB | Drtbalu | |
| 04:38, 23 October 2018 | Stylo.jpg (file) |  |
85 KB | Drtbalu | |
| 04:37, 23 October 2018 | Para space1 .jpg (file) |  |
93 KB | Drtbalu | |
| 04:37, 23 October 2018 | Para mass.jpg (file) |  |
85 KB | Drtbalu | |
| 04:33, 23 October 2018 | Mr glossitis.jpg (file) |  |
21 KB | Drtbalu | |
| 04:31, 23 October 2018 | Parotid tumor .jpg (file) |  |
88 KB | Drtbalu | |
| 01:43, 23 October 2018 | Ctlud.jpg (file) |  |
41 KB | Drtbalu | |
| 01:42, 23 October 2018 | Mandible.jpg (file) |  |
6 KB | Drtbalu | |
| 01:42, 23 October 2018 | Spaces.jpg (file) |  |
100 KB | Drtbalu | |
| 01:41, 23 October 2018 | Submandibular space.jpg (file) |  |
64 KB | Drtbalu | |
| 01:41, 23 October 2018 | Ludwigs.jpg (file) |  |
52 KB | Drtbalu | |
| 15:52, 22 October 2018 | Levels.jpg (file) |  |
14 KB | Drtbalu | |
| 15:41, 22 October 2018 | Cfv-lpr.jpg (file) |  |
23 KB | Drtbalu | |
| 15:37, 22 October 2018 | Comb lcele.jpg (file) |  |
45 KB | Drtbalu | |
| 15:37, 22 October 2018 | Int cele.jpg (file) |  |
47 KB | Drtbalu | |
| 12:19, 22 October 2018 | Glottis frac.jpg (file) |  |
42 KB | Drtbalu | |
| 12:18, 22 October 2018 | Supra glot.jpg (file) |  |
42 KB | Drtbalu | |
| 12:14, 22 October 2018 | Fract larynx.jpg (file) |  |
60 KB | Drtbalu | |
| 08:53, 22 October 2018 | Granuloma.jpg (file) |  |
66 KB | Drtbalu | |
| 08:52, 22 October 2018 | Intub inju.jpg (file) |  |
81 KB | Drtbalu | |
| 08:52, 22 October 2018 | Et .jpg (file) |  |
57 KB | Drtbalu | |
| 07:17, 22 October 2018 | Hashi his.JPG (file) | |
11 KB | Drtbalu | |
| 07:16, 22 October 2018 | Hashi.jpg (file) |  |
5 KB | Drtbalu | |
| 02:23, 17 October 2018 | Hbo.jpg (file) |  |
107 KB | Drtbalu |